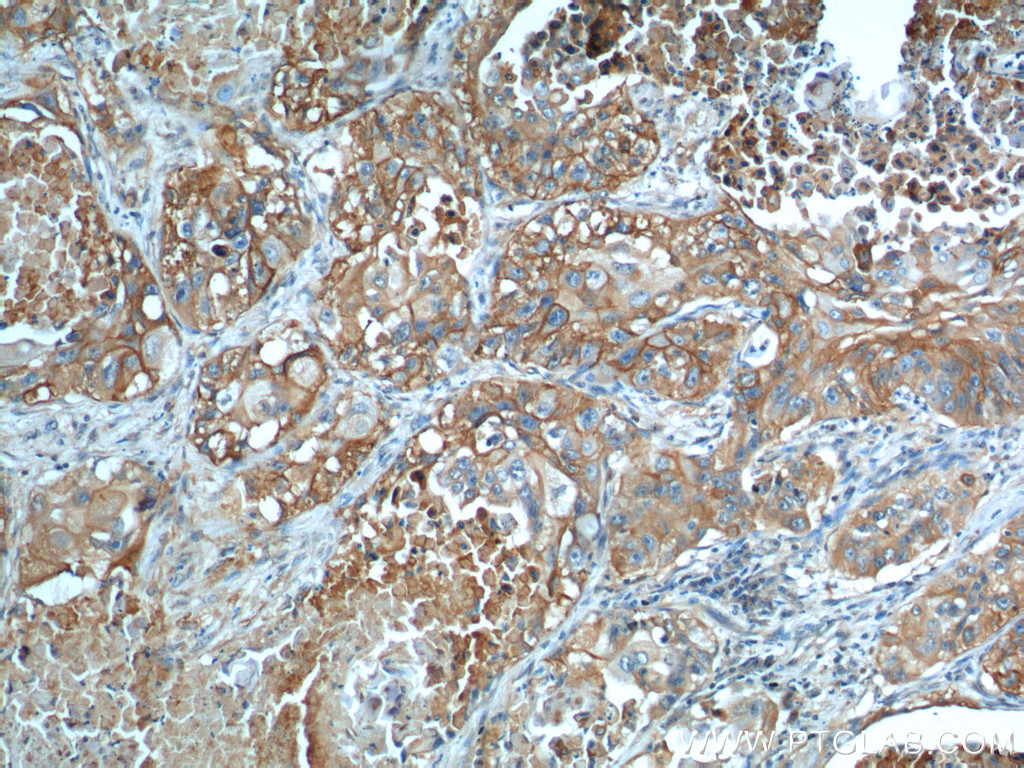

验证数据展示
经过测试的应用
| Positive WB detected in | HEK-293 cells |
| Positive IHC detected in | human lung cancer tissue, human rectal cancer tissue Note: suggested antigen retrieval with TE buffer pH 9.0; (*) Alternatively, antigen retrieval may be performed with citrate buffer pH 6.0 |
| Positive IF-P detected in | human lung cancer tissue, human placenta tissue |
| Positive FC (Intra) detected in | Jurkat cells |
推荐稀释比
| 应用 | 推荐稀释比 |
|---|---|
| Western Blot (WB) | WB : 1:500-1:3000 |
| Immunohistochemistry (IHC) | IHC : 1:1000-1:4000 |
| Immunofluorescence (IF)-P | IF-P : 1:200-1:800 |
| Flow Cytometry (FC) (INTRA) | FC (INTRA) : 0.40 ug per 10^6 cells in a 100 µl suspension |
| It is recommended that this reagent should be titrated in each testing system to obtain optimal results. | |
| Sample-dependent, Check data in validation data gallery. | |
产品信息
66290-1-Ig targets GLUT1 in WB, IHC, IF-P, FC (Intra), ELISA applications and shows reactivity with human samples.
| 经测试应用 | WB, IHC, IF-P, FC (Intra), ELISA Application Description |
| 文献引用应用 | WB, IHC, IF |
| 经测试反应性 | human |
| 文献引用反应性 | human, rat |
| 免疫原 |
CatNo: Ag17108 Product name: Recombinant human SLC2A1,GLUT1 protein Source: e coli.-derived, PET28a Tag: 6*His Domain: 216-280 aa of BC121804 Sequence: INRNEENRAKSVLKKLRGTADVTHDLQEMKEESRQMMREKKVTILELFRSPAYRQPILIAVVLQL 种属同源性预测 |
| 宿主/亚型 | Mouse / IgG1 |
| 抗体类别 | Monoclonal |
| 产品类型 | Antibody |
| 全称 | solute carrier family 2 (facilitated glucose transporter), member 1 |
| 别名 | SLC2A1, 2A5A2, GLUT-1, SLC2A1,GLUT1 |
| 计算分子量 | 492 aa, 54 kDa |
| 观测分子量 | 45-55 kDa |
| GenBank蛋白编号 | BC121804 |
| 基因名称 | GLUT1 |
| Gene ID (NCBI) | 6513 |
| RRID | AB_2881673 |
| 偶联类型 | Unconjugated |
| 形式 | Liquid |
| 纯化方式 | Protein G purification |
| UNIPROT ID | P11166 |
| 储存缓冲液 | PBS with 0.02% sodium azide and 50% glycerol, pH 7.3. |
| 储存条件 | Store at -20°C. Stable for one year after shipment. Aliquoting is unnecessary for -20oC storage. |
背景介绍
Glucose transporter 1 (GLUT1), also known as solute carrier family 2, facilitated glucose transporter member 1 (SLC2A1), is a uniporter protein responsible for the transport of glucose in many cell types and across the blood-brain barrier.
What is the molecular weight of GLUT1? Is GLUT1 post-translationally modified?
There are two forms of GLUT1 transporter that differ in their molecular weight. The 45-kDa form is found in glial cells, while the 55-kDa form is present in the endothelial cells regulating glucose transport over the blood-brain and blood-tissue barriers (PMID: 9630522). N-glycosylation of asparagine at position 42 is the only known post-translation modification of GLUT1 (PMID: 3839598).
What is the subcellular localization of GLUT1?
Glucose transporters, including GLUT1, are multiple-pass integral membrane proteins. GLUT1 is present at the plasma membrane but is also a subject of recycling between plasma membrane and endosomes.
What molecules can be transported by GLUT1?
The main substrate of GLUT1 transport is glucose, but it can also transport galactose, mannose, glucosamine, and reduced ascorbate.
What is the tissue expression pattern of GLUT1?
GLUT1 is expressed by many cell types but the highest levels are observed in erythrocytes and in the central nervous system (astrocytes). GLUT1 is responsible for glucose transfer across the blood-brain and blood-tissue barriers, including placental transport.
实验方案
| Product Specific Protocols | |
|---|---|
| FC protocol for GLUT1 antibody 66290-1-Ig | Download protocol |
| IF protocol for GLUT1 antibody 66290-1-Ig | Download protocol |
| IHC protocol for GLUT1 antibody 66290-1-Ig | Download protocol |
| WB protocol for GLUT1 antibody 66290-1-Ig | Download protocol |
| Standard Protocols | |
|---|---|
| Click here to view our Standard Protocols |
发表文章
| Species | Application | Title |
|---|---|---|
Cell Metab Acetate enables metabolic fitness and cognitive performance during sleep disruption | ||
Cell Metab Di-methylation of CD147-K234 Promotes the Progression of NSCLC by Enhancing Lactate Export. | ||
ACS Nano Dual Inhibition of Endoplasmic Reticulum Stress and Oxidation Stress Manipulates the Polarization of Macrophages under Hypoxia to Sensitize Immunotherapy. | ||
ACS Nano Choline Phosphate-Grafted Nanozymes as Universal Extracellular Vesicle Probes for Bladder Cancer Detection | ||
Mol Cell TCR activation directly stimulates PYGB-dependent glycogenolysis to fuel the early recall response in CD8+ memory T cells. | ||
Nat Commun Fasting inhibits aerobic glycolysis and proliferation in colorectal cancer via the Fdft1-mediated AKT/mTOR/HIF1α pathway suppression. |